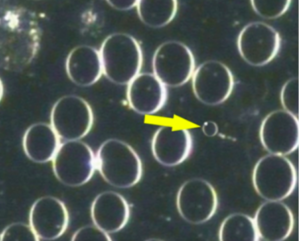

The mychit is the bacterial form that progresses from the colloid thecit. It appears in darkfield as a sphere, varying in size from very small to the size of a RBC, with one stationary nucleus in the cell wall. The upward development of mychits into higher pathogenic forms involves a process by which a basit is formed. The mychit doubles, resulting in a dimychit, and then resolves into a pure tubule, called a basit (the basit is much shorter than an ascit). Mychits can also arrange themselves into chains, called mychit chains or desme.
Appearance
The mychit is the bacterial form that progresses from the colloid thecit. It appears in darkfield as a sphere, varying in size from very small to the size of a RBC, with one stationary nucleus in the cell wall. The upward development of mychits into higher pathogenic forms involves a process by which a basit is formed. The mychit doubles, resulting in a dimychit, and then resolves into a pure tubule, called a basit (the basit is much shorter than an ascit). Mychits can also arrange themselves into chains, called mychit chains or desme.
Pleomorphic Perspective
Mychits are formed when a symprotit arranges nutritional reserves around it to create a cell. The symprotit is the nucleus or mych of the mychit. The mychit is the primary germ cell, or the morphological base unit, of bacteria. From here, the nucleus can divide into two and the cell can elongate, forming a dimychit. The dimychit can then undergo further elongation, along with further division of the nucleus, until the ascit stage is reached, where thirty-two nuclei are arranged linearly in the mycascit and arranged three-dimensionally in the synascit.
Implications
The presence of these primitive bacterial forms is an indication of a move towards dysbiosis and the bacterial phase of the endobiont’s life cycle.